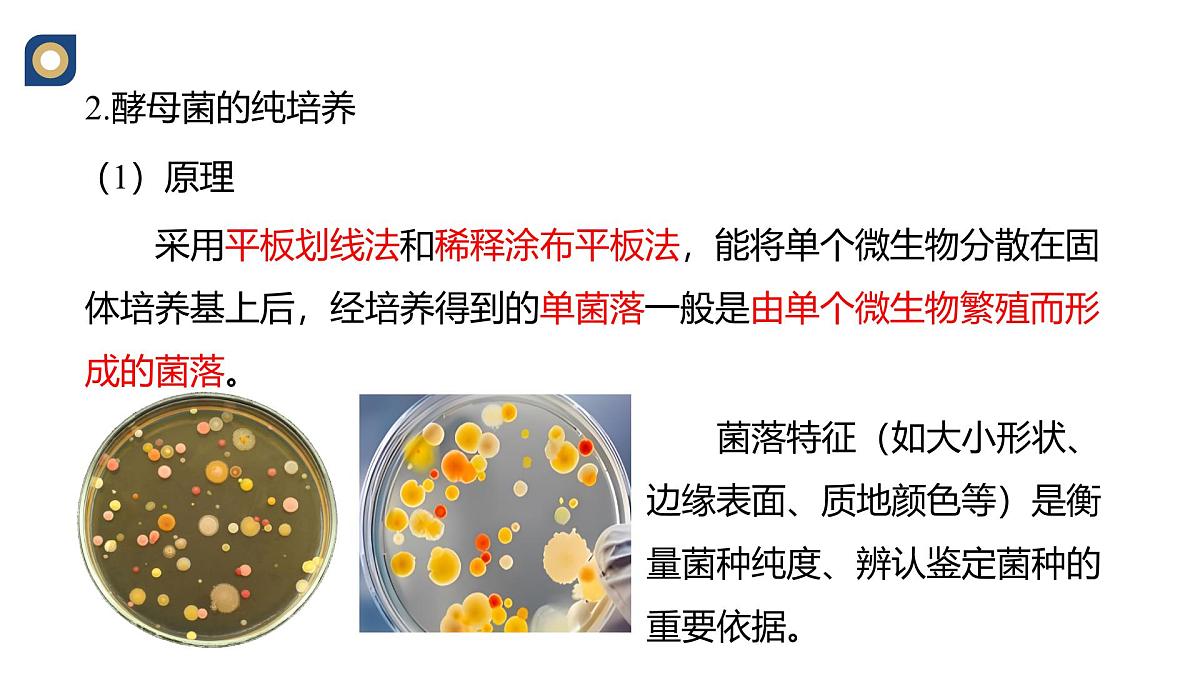
人教版高中生物选修3 1-2《微生物的基本培养技术（第2课时）》教学课件第2页

所属成套资源:人教版高中生物选修3 课件+教案+试题
人教版 (2019)选择性必修3微生物的基本培养技术教学课件ppt
展开
这是一份人教版 (2019)选择性必修3微生物的基本培养技术教学课件ppt,共44页。PPT课件主要包含了酵母菌的纯培养,1原理,2材料用具,①配制培养基,3方法步骤,②灭菌,③倒平板,课堂练习,培养基,高压蒸汽灭菌等内容,欢迎下载使用。
采用平板划线法和稀释涂布平板法,能将单个微生物分散在固体培养基上后,经培养得到的单菌落一般是由单个微生物繁殖而形成的菌落。
菌落特征(如大小形状、边缘表面、质地颜色等)是衡量菌种纯度、辨认鉴定菌种的重要依据。
称取去皮的马铃薯200g
加水1000mL,加热煮沸至马铃薯软烂
向滤液加入20克葡萄糖用玻棒搅拌以加速溶解
分瓶后各加琼脂摇匀,包瓶口并用橡皮筋勒紧
用纱布过滤后,加蒸馏水至1000mL
加棉塞、包牛皮纸、橡皮筋勒紧
培养基装入锥形瓶,加棉塞,包牛皮纸扎紧,高压蒸汽灭菌
培养皿5~8套作一包,放于干热灭菌箱内灭菌
100KPa121℃下维持15-30min
哪经配制、灭菌的培养基可即给微生物“大餐”了吗,还需要什么环节?了解各步骤的注意问题有哪些?
经烹调的菜式,需要上盘分餐以便供客人用餐食用。
培养基冷却到50℃左右时,在酒精灯火焰附近倒平板。
①在火焰旁,右手拿锥形瓶,左手拔出棉塞;
思考1.培养基灭菌后,需要冷却到50 ℃左右时,才能用来倒平板。你用什么办法来估计培养基的温度?
可用手触摸盛有培养基的锥形瓶,感觉锥形瓶的温度下降到刚刚不烫手时,就可以进行倒平板了。
②右手拿锥形瓶,使瓶口迅速通过火焰
③左手将培养皿打开缝隙,右手将培养基倒入培养皿,即盖上皿盖。
思考2.为什么需要使锥形瓶的瓶口通过火焰?
通过灼烧灭菌,防止瓶口的微生物污染培养基。
④待平板冷却凝固后,将平板倒过来放置。
思考3.平板冷凝后,为什么要将平板倒置?
平板冷凝后,皿盖上会凝结水珠,凝固后的培养基表面的湿度也比较高,将平板倒置,既可以使培养基表面的水分更好地挥发,又可以防止皿盖上的冷凝水珠落入培养基,造成污染。
1.下列关于制备酵母菌固体培养基的说法,错误的是( )A.操作顺序为称量、煮沸至软烂、倒平板、灭菌B.将煮至软烂的马铃薯用纱布过滤至烧杯中 C.待培养基冷却至50℃左右时进行倒平板D.待平板冷却凝固5~10 min后将平板倒过来放置
2.制备酵母菌固体培养基的步骤是( )
A.称量、倒平板、煮沸至马铃薯软烂、灭菌B.称量、煮沸至马铃薯软烂、倒平板、灭菌
C.称量、煮沸至马铃薯软烂、灭菌、倒平板D.称量、灭菌、煮沸至马铃薯软烂、倒平板
3.制作酵母菌培养基时,倒平板操作的步骤是:将灭过菌的培养皿放在火焰旁的桌面上,右手拿装有培养基的锥形瓶,左手拔出______;右手拿锥形瓶,将______迅速通过火焰;用左手的拇指和食指将培养皿打开一条稍大于瓶口的缝隙,右手将锥形瓶中的_______倒入培养皿,左手立即盖上培养皿的皿盖;等待平板冷却______后,将平板倒过来放置,使______在下、_______在上。
(1)从成分上来说,该培养基中除了水和无机盐,牛肉膏和蛋白胨为大肠杆菌既能提供_______,又能提供_______。(2)培养大肠杆菌前,需要将培养基进行严格的灭菌处理,常用的方法是_______________。(3)若大幅度提高培养基中NaCl的含量,可用于筛选耐盐的细菌,这种培养基被称为_______培养基。
4.某兴趣小组制备牛肉膏蛋白胨固体培养基并用来培养大肠杆菌,牛肉膏蛋白胨固体培养基的配方如下表。请分析回答有关问题:
(二)接种和分离酵母菌
培养基“大餐”准备完毕,怎样把微生物客人邀请过来呢?
为何播种时要逐粒将豆子散播中土中?
通过接种环在琼脂固体培养基表面连续划线的操作,将聚集的菌种逐步稀释分散到培养基的表面。在数次划线后培养,可以分离到由一个细胞繁殖而来的肉眼可见的子细胞群体。
1.将接种环放在火焰上灼烧,直到接种环烧红。
2.在火焰旁冷却接种环,并打开盛有菌液的试管的棉塞。
操作前灼烧接种环是为了避免接种环上可能存在的微生物污染培养物。
思考1.为什么在操作前要灼烧接种环?
3.将试管口通过火焰。
目的是经灼烧灭菌,防止试管口的微生物污染菌种。
4.将已冷却的接种环伸入菌液中,沾取一环菌液。
冷却的目的是避免接种环温度太高而杀死菌种。
5.将试管口通过火焰,并塞上棉塞。
6.左手将皿盖打开一条缝隙,右手将沾有菌种的接种环迅速伸入平板内,划三到五条平行线。
7.灼烧接种环,待其冷却后,从第一区域划线的末端开始往第二区域内划线。重复以上操作。
思考1:每次划线之前都要灼烧接种环?
杀死上次残留的菌种,保证使下一次划线时,菌种直接来源于上次划线的末端,从而通过划线次数的增加,使每次划线时菌种的数目逐渐减少,以便得到菌落。
思考3. 为什么要从上一次划线的末端开始划线?
划线后,线条末端细菌的数目比起始处要少,每次从上一次划线的末端开始,能使细菌的数目随着划线次数的增加而逐步减少,最终能得到由单个细菌繁殖而来的菌落。
思考1:划线操作结束时,为何仍要烧接种环?
及时杀死接种环上残留的菌种,避免细菌污染环境和感染操作者。
①接种环只蘸一次菌液,但要在培养基不同位置连续划线多次。②划线首尾不能相接。③划线时不要划破培养基。
接种后的培养基与一空白培养基倒置放入37℃的恒温箱中培养12h~24h。
设置空白培养基的有何作用?
培养基倒置有何目的?
倒置可防止皿盖上的冷凝水珠落入培养基,造成污染。
1.有关平板划线操作正确的是( )A.使用已灭菌的接种环、培养皿,操作过程中不再灭菌B.打开含菌种的试管需通过火焰灭菌,取出菌种后需马上塞上棉塞C.将沾有菌种的接种环迅速伸入平板内,划三至五条平行线即可D.最后将平板倒置,放入培养箱中培养
2.微生物接种方法很多,平板划线法是最常用的一种。如图是平板划线示意图,划线的顺序为①②③④。下列操作方法错误的是( )A.划线操作时,将沾有菌种的接种环插入培养基B.平板划线后培养微生物时要倒置培养C.不能将第④区域的划线与第①区域的划线相连D.在②~④区域中划线前后都要对接种环进行灭菌
3.如图为微生物的实验室培养和纯化醋酸菌的部分操作步骤,请回答下列问题:
(1)①是制备培养基时_________的操作,该操作需待培养基冷却至______左右时,在______________附近附近进行.
(2)该实验中纯化醋酸菌的接种方法是___________;在完成步骤④的操作中,在每次划线之前都要_____________,使得每一次划线时接种环上的菌种直接来源于________________。
(1)微生物所需的营养成分包括_______、_______、水和无机盐。
(2)培养微生物时,除考虑微生物生长所需的营养外,还要考虑微生物生长所需的温度、_____以及是否需要O2等。
4.下图表示为平板划线法分离纯化细菌示意图。根据所学生物学知识,完成下列问题。
(3)对培养基进行灭菌时,多采用_______________法,而对接种环或涂布器灭菌时则用____________法。
(4)平板划线时,为保证每次划线都从上次划线末端的微生物浓度开始,所以每次划线前都要__________________,平板划线结束后,最后一次划的线不能与第一次划的线_________。
将菌液进行一系列梯度稀释,然后将不同稀释度的菌液分别涂布到琼脂固体培养基的表,进行培养。在稀释度足够高的菌液里,聚集在一起的微生物将被分散成单个细胞,从而能在培养基表面形成单个菌落。
注意:移液管需要经过灭菌;试管口和移液管离火焰1~2cm处。
1.将涂布器浸在盛有70% 的酒精的烧杯中。
2.取少量菌液滴加到培养基表面。
3.将涂布器多余的酒精在烧杯中滴尽,后移到酒精灯火焰上小心引燃其沾有的少量酒精。
4.用涂布器将菌液均匀地涂布在培养基表。
思考:涂布平板的所有操作都应在火焰附近进行。结合平板划线与系列稀释的无菌操作要求,想一想,第2步应如何进行无菌操作?
应从操作的各个细节保证“无菌”。如:酒精灯与培养皿的距离要合适、 吸管头不要接触任何其他物体、 吸管要在酒精灯火焰周围等等。
每个浓度做3个涂布平板
接种的培养基倒置放入37℃的恒温箱中培养12h~24h
3.平板划线法和稀释涂布平板法的比较
可观察菌落特征,对混合菌进行分离
可计数,可观察菌落特征
吸收量较少、较麻烦,平板不干燥效果不好,容易蔓延
适用于厌氧菌和兼性厌氧菌
1.牛肉膏蛋白胨固体培养基叙述正确是( )A.牛肉膏和蛋白胨都能提供碳源、氮源、磷酸盐、维生素B.牛肉膏蛋白胨培养基需经高压蒸汽灭菌后调节pHC.该培养基配方中,有机物含量多、无机盐含量少D.该培养基中加入少量水即可制成液体培养基
2.分离纯化大肠杆菌最常用的方法是平板划线法和稀释涂布平板法。下列有关这两种方法的叙述错误的是( )A.均将大肠杆菌接种在固体培养基的表面B.获得的每个菌落均是由一个细菌繁殖而来的子细胞群C.都应在火焰附近进行操作,以防止杂菌污染D.稀释分散菌种的原理不同,均能达到分离纯化大肠杆菌的目的
3.下图甲、乙是微生物接种常用的两种方法,请回答相关问题:(1)图甲是利用____________法进行微生物接种,图乙是利用________________法进行微生物接种。这两种方法所用的接种工具分别是________和________;对这两种接种工具进行灭菌和消毒的方法依次是___________和酒精消毒。
(2)接种操作为什么一定要在火焰附近进行?__________________________(3)接种后,在固体培养基上培养细菌时为什么进行倒置培养?________________________________________。(4)如图是采用上述接种方法接种后培养的效果图解,其接种方法是________(填图甲或图乙)。
火焰附近存在着无菌区域。
避免培养过程产生的水分影响微生物的生长
4.回答下列问题: (1)在大肠杆菌培养过程中,除考虑营养条件外,还要考虑______、________和渗透压等条件。由于该细菌具有体积小、结构简单、变异类型容易选择、________、____________等优点,因此常作为遗传学研究的实验材料。 (2)在微生物培养操作过程中,为防止杂菌污染,需对培养基和培养皿进行________(消毒、灭菌);操作者的双手需要进行清洗和______;静止空气中的细菌可用紫外线杀灭,其原因是紫外线能使蛋白质变性,还能_______________。
相关课件
这是一份人教版 (2019)选择性必修3微生物的基本培养技术教学课件ppt,共44页。PPT课件主要包含了酵母菌的纯培养,1原理,2材料用具,①配制培养基,3方法步骤,②灭菌,③倒平板,课堂练习,培养基,高压蒸汽灭菌等内容,欢迎下载使用。
这是一份高中生物人教版 (2019)选择性必修3微生物的基本培养技术教学课件ppt,共19页。PPT课件主要包含了从社会中来,微生物,非细胞类,霉菌等,原生生物,类病毒等,培养基,无菌技术,基本成分,1碳源等内容,欢迎下载使用。
这是一份高中生物人教版 (2019)选择性必修3微生物的基本培养技术评课课件ppt,共26页。PPT课件主要包含了问题探讨,无细胞结构生物,原核生物,真核生物,培养基的配置,3培养基的类型,培养基的配制,自养微生物,异养微生物,无菌技术等内容,欢迎下载使用。
相关课件 更多
- 1.电子资料成功下载后不支持退换,如发现资料有内容错误问题请联系客服,如若属实,我们会补偿您的损失
- 2.压缩包下载后请先用软件解压,再使用对应软件打开;软件版本较低时请及时更新
- 3.资料下载成功后可在60天以内免费重复下载
 免费领取教师福利
免费领取教师福利







.png)




